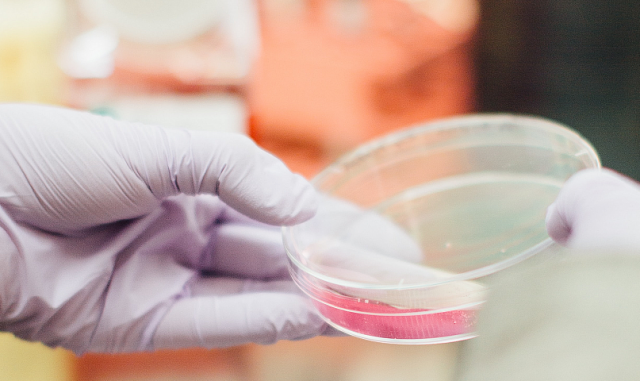

Testy na miejscu
16 li. 2020 - 09:12 – red. wydania: meszczynska@rc.fm
Jest aparatura wraz z komorą laminarną, jest i ministerialny certyfikat - lada dzień kaliski szpital rozpoczyna testowanie pacjentów i personelu na miejscu, bez konieczności wysyłania próbek do laboratoriów w dużych ośrodkach.
"Wystąpiliśmy do Ministerstwa Zdrowia o wpisanie naszego laboratorium na listę laboratoriów covidowych i przeszliśmy pozytywnie weryfikację. Na biurku mam również do podpisu umowę z Narodowym Funduszem Zdrowia, na refundację kosztów związanych z wykonywaniem tych testów. Będą one u nas niebawem wykonywane, procedury muszą zostać jednak zachowane" - mówi radiuCENTRUM Radosław Kołaciński, dyrektor szpitala w Kaliszu. W pierwszej kolejności szybkie testy będą realizowane na potrzeby pacjentów trafiających na oddziały kaliskiego szpitala: "Wydajność tego urządzenia to jest około 90 testów na dobę. Jeden test można przeprowadzić w ciągu około 45 minut. Pacjenci, którzy leżą np. na części obserwacyjnej SOR-u, gdy otrzymają szybko wyniki, a będą one dodatnie - mogą być niezwłocznie przekazywani w dedykowane miejsca, czyli na łóżka covidowe w naszym szpitalu czy szpitalach jednoimiennych. W ten sposób sprawnie zwalniane będą miejsca dla pacjentów oczekujących w kolejce" - dodaje dyrektor.

Autor:

Personalia
- redakcja@rc.fm
Nazwisko:

NEWS nr 2:
Każde forum komentarzy umieszczone pod informacjami prasowymi na niniejszej stronie internetowej (www.rc.fm), nie jest moderowane w czasie rzeczywistym - komentarze nie są weryfikowane przed ich automatyczną publikacją. Nie jest dozwolone umieszczanie w ww. komentarzach: nazw i marek o charakterze komercyjnym, linków czy innego rodzaju przekierowań do innych stron internetowych i jakichkolwiek obiektów graficznych. Wpisy łamiące prawo należy zgłaszać na adres: adm@rc.fm. Wpisując jakikolwiek komentarz na niniejszej stronie internetowej (www.rc.fm), autor tego komentarza przyjmuje świadomie do wiadomości i świadomie akceptuje bezwarunkowe prawo właściciela niniejszej strony internetowej (www.rc.fm) do usunięcia lub modyfikacyjnego skrótu wpisanego komentarza oraz brak gwarancji zapewnienia ciągłości publikacji wpisanego komentarza, jako korespondencji niezamówionej przez właściciela niniejszej strony internetowej (www.rc.fm).






















